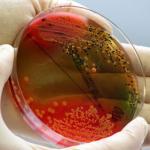
Više od 20 dece zaraženo salmonelom u Valjevu

Izvor: RTS, 28.Sep.2009, 21:55 (ažurirano 02.Apr.2020.)
Više od 20 dece zaraženo salmonelom u Valjevu
Zavod za javno zdravlje u Valjevu proglasio je epidemiju salmonele u dečjoj ustanovi u tom gradu, jer je od nje obolelo 24 dece. Naložen je pregled osoblja, objekata i hrane koja se sprema za decu.
U dečjoj ustanovi u Valjevu proglašena je epidemija salmonele jer je ona konstatovana kod dvadesetčetvoro dece, saopštio je Zavod za javno zdravlje u tom gradu.
Direktorka Zavoda dr Marija Gavrilović rekla je Tanjugu da je oboljenje potvrđeno kod desetoro dece, a sumnja >> Pročitaj celu vest na sajtu RTS << se da bi moglo biti mnogo više zaraženih.
Gavrilovićeva nije mogla da kaže šta je uzrok zaraze, navodeći da su analize obolelih u toku, a da do sada, u uzetim uzorcima hrane, nije pronađena salmonela.
Naložen je pregled osoblja, zatim svih sedam objekata u kojima su smeštena deca, opreme, kuhinje - u kojoj se priprema više od 5.000 obroka i svega ostalog što bi moglo da bude sumnjivo za uzrok ove bolesti, kao i hrane koja se priprema u objektima.
Načelnica Republičke sanitarne ispekcije za Kolubarski okrug Branka Miholjčić rekla je da će tek kada se utvrdi uzrok zaraze biti preduzete određene mere prema odgovornima, a dotle je naloženo poboljšanje higijenskih uslova, dezinfekcije objekata u kojima se priprema hrana, ali i lične higijene zaposlenih.
Odgovorni iz te ustanove nisu se oglašavali u vezi sa tim, ali se očekuje da će to uskoro učiniti.











